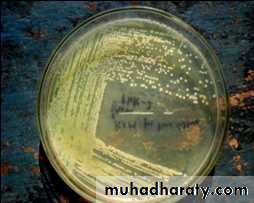
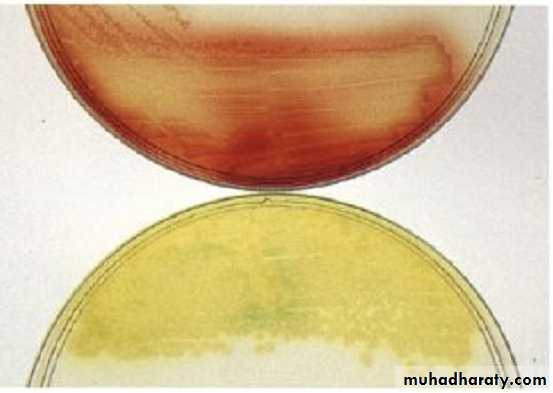
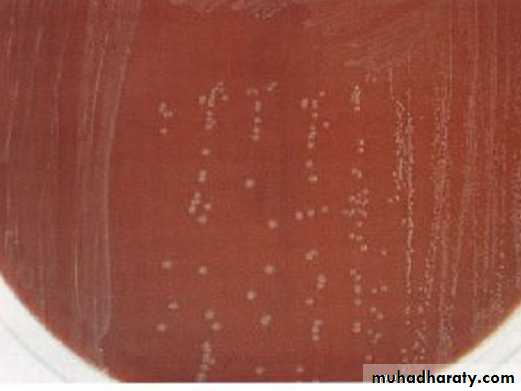
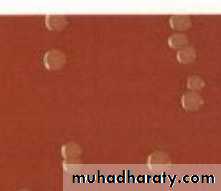
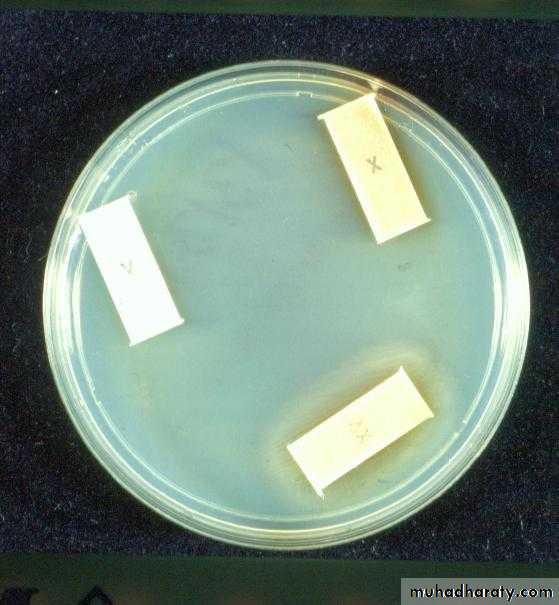
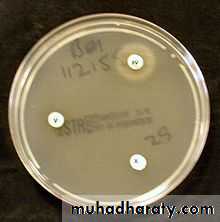
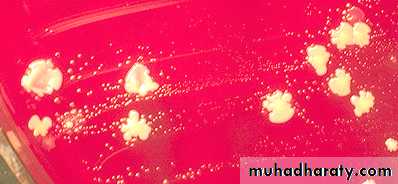
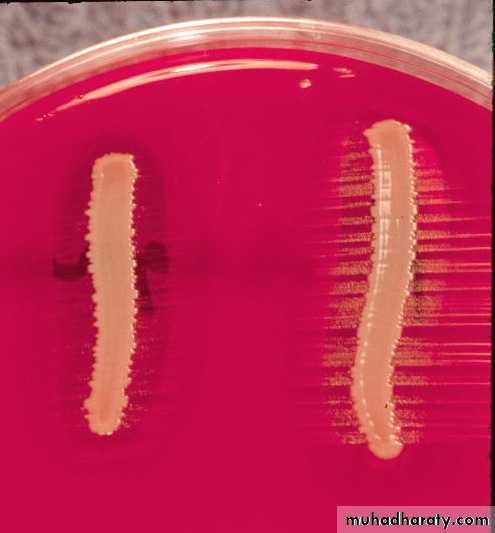

Non Enteric Gram negative rodspseudomonas spphaemophilus sppbrucella mycobacteria
Pseudomonas aeruginosaIs widely distributed in nature and is commonly present in moist environment in hospitals.
It can colonize normal human, in whom it is a saprophyte.
It cause disease in immuno-compromised individuals or when they gain access to a normally sterile body site through trauma
( it is an opportunistic pathogen).
Cont/..Pseudomonas aeruginosa
Microscopical appearance :Gram-negative rods, Motile (by single or multiple polar flagella) ,measuring 0.6*2 µm.
Occurs as single bacterium, in pairs, occasionally as short chain
Cont/.. Pseudomonas aeruginosa
Cultural (Macroscopic) characteristics: Pale white or translucent colonies .Circular, convex, and smooth colonies. Obligate aerobes, grow readily on many types of media, on blood it gives β-hemolysis, sometimes producing a sweet or grape -like odor.• Cont/.. Pseudomonas aeruginosa
• Exopigments:Many strains of P aeruginosa produce:
Fluorescent greenish color pyoverdin
It often produces:
non-fluorescent bluish pigment pyocyaninSome strains produce:
Dark red pigment pyorubin or black pigment pyomelanin
• Cont/.. Pseudomonas aeruginosaIt grows well at 37-42 °C; its growth at 42 °C helps differentiate it from other Pseudomonas spp in the flourescent group.
Biochemical Tests :
Oxidase Test =+ve,
IMViC= _ _ _+ ,
Gelatin = +ve,
TSI = - - - -
Catalase =+ve
It does not ferment carbohydrates, but many strains oxidize glucose
Summary
Identification of P aeruginosa is based on1-colony morphology
2-oxidase positivity
3-the presence of characteristic pigments
4-growth at 42 °C
Haemophilus spp
The most common type of Haemophilus spp. is type b H influenzae.Microscopical appearance:
Gram-negative, pleomorphic, coccobacilli, non motile. Some strains are capsulated some are not. The organisms are short (1.5 µm).
Cont/…Haemophilus influenzae
Cultural(macroscopical) characteristics:This microorganism is very fastidious in its growth that need enriched media. The preferable medium for culturing Heamophilus spp is chocolate agar on which it would give flat, grayish – brown colonies with diameter of 1-2mm at 37°C
Cont/…Haemophilus influenzae
Growth characteristicsOn blood agar, Haemophilus group required certain growth factors called X factor( that would act as Hemin);and ̸ or V factor that would act as a coenzyme (NAD or nicotinamide adenine nucleotide)
Cont/…Haemophilus influenzae
These growth requirements are used for differentiation of Heamophillus spp.Hemolysis
RequiresX V
species
-
+ +
H influenzae
-
- +
H parainfluenzae
+
+ +
H haemolyticus
It can grow around Staphylococcus aureus streak yielding the satellite phenomenon because Staphylococci would cause the release of NAD and the Hemin from the blood in the agar which allow the Heamophilus to grow just around the colonies of Staph.
Cont/…Haemophilus influenzae
Biochemical test:Catalase: positive
Oxidase: positive – slow reaction.
Cont/…Haemophilus influenzae
Brucellae sppThe Brucellae are obligate parasites of animals and humans and are charecterisically located intracellularly.
The disease in human is brucellosis (Malta fever).
Brucellosis is a zoonotic disease caused by any of four Brucellae species.
Cont/..Brucellae spp
Microscopical appearance:Gram negative coccobacillary , aerobic , non motile, non spore forming.
Cultural(macroscopical ) appearance: Cultured on blood agar and chocolate agar. Grows as tiny gray-white, shiny ,small convex colonies on blood agar. Brucellae utilize carbohydrate without gas or acid production.
It is a slow growing m.o. that necessitate a rapid method for identification by using serological method (Rose Bengal test).
• Cont/..Brucellae spp
Biochemical test :
Catalase =+ ve,oxidase =+ ve,
nitrate reduction= +ve .
urease =+ ve
No carbohydrate fermentation.
• Cont/..Brucellae spp
Serological test(indirect latex agglutination):
1-The Rose Bengal Test (RBT) is the most widely used screening test for brucellosis in both humans and animals owing to its apparent simplicity of reading .Principle of the test:
A rapid agglutination slide test for the detection of Brucellae specific antibody. A suspension of Brucellae possessing active antigen will agglutinate when exposed to homologous Brucellae antibody. This agglutination forms clumps of bacteria which becomes macroscopically visible. The Rose Bengal stained Brucellae antigen is used for the early detection of Brucellae.
• Cont/..Brucellae spp
The Rose Bengal Test (RBT)The reagent: Rose Bengal ( rose color stain)
Result:
Negative: No agglutination
Positive: (Presence of Specific Antibodies) agglutination.
2- brucilline skin test: non specific used in chronic cases give an indication for past or present infection.
• Cont/..Brucellae spp
Mycobacteria spp
The mycobacteria are rod-shaped, aerobic, non-spore forming bacteria.Mycobacterium tuberculosis
Microscopical appearance:
Thin straight rods measuring about 0.4x3 µm.
Mycobacteria cannot be classified as either gram +ve or gram –ve.
Tubercle bacilli are characterized by “acid-fastness”-ie, 95% ethyl alcohol containing 3% HCl (acid-alcohol) quickly decolorizes all bacteria except the mycobacteria. Acid-fastness depends on the integrity of the waxy envelope.
The Ziehl-Neelsen (acid-fast) stain is used for identification of acid-fast bacilli.
Cont/…M tuberculosis
Macroscopical appearance:Culturing of mycobacteria requires both a non-selective and a selective media. Selective media contain antibiotics to prevent overgrowth of contaminating bacteria and fungi.
There are three general formulations :
1- Semisynthetic Agar Media (eg, Middlebrook 7H10).
2- Inspissated Egg Media (eg, Lowen-stein-Jensen).
3- Broth Media (eg, Middlebrook 7H9).
Growing of Mycobacteria on these media is slow and requires prolonged time (over weeks).
Tuberculin skin test:
Principle: a large amount of tuberculin injected IC into hypersensitive host may give rise to severe local reaction.An individual who has had a primary infection with tubercle bacilli develops induration, edema and erythema within 24-48 hrs. The test should be read in 48-72 hrs.
In a person who has not had contact with tubercle bacilli, no reaction to the skin test results.